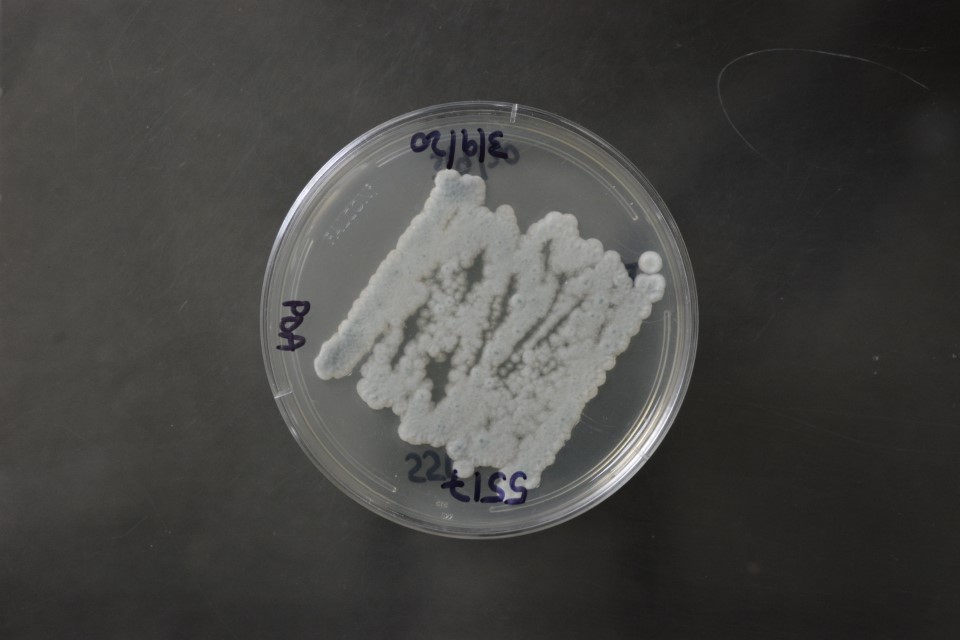

Aspergillus fumigatus
NRRL 5517
Accession numbers in other collections:ATCC 22268=BKM F-1488=CBS 158.71=QM 9695
Source:BKM,USSR
Isolated from(substrate):Soil
Substrate location:USSR
Growth media:Potato Dextrose Agar(number 3)
Optimum growth temperature:25C
Strain images:
NRRL_5517_3_reverse.JPG

NRRL_5517_3_top.JPG

Comments:type of A.anomalus Pidoplichko&Kirilenko,later homonym of A.anomalus Mosseray(aspergillus niger gp)
NRRL5517